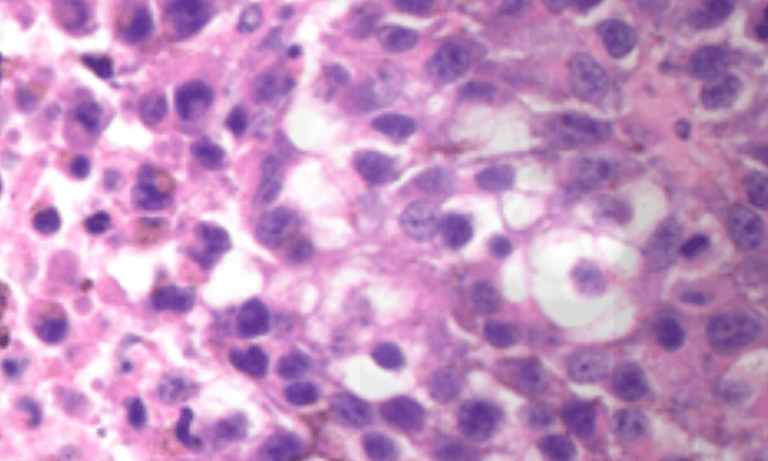
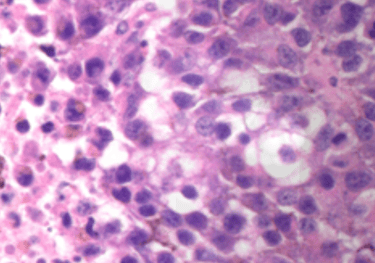

Links and Info
Some links that are interesting to me and may be useful to you. Please email me if you have more to recommend
International Immunogenetic Information System
Resources for students of the adaptive immune response




UniProt
Database for protein structure


Zumutor Biologics
I'm on the Scientific Advisory Board of the great team at Zumutor: home of the INABLR platform for antibody discovery. Send me a message for more information.